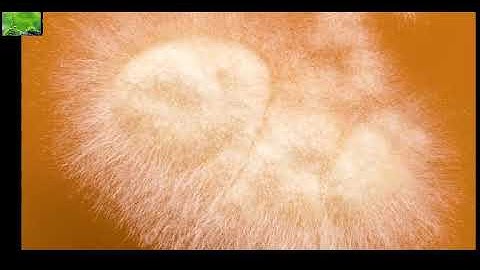
Sự biến đối kì diệu của nấm móc

⬇ DOWNLOAD NOW
Kalau muncul iklan pop-up, tutup lalu klik tombol kembali
Download lagu Công nghệ PCI – Ức chế sự phát triển của nấm mốc / Reducing Growth of Mold secara gratis hanya untuk keperluan promosi. Dukung artis favorit kamu dengan membeli musik original di iTunes atau platform resmi lainnya.
 Công nghệ PCI – Loại bỏ bùi khó chịu / Reducing Odor
Công nghệ PCI – Loại bỏ bùi khó chịu / Reducing Odor
 #002 Điều gì xảy ra khi ăn phải nấm mốc - Mold ?
#002 Điều gì xảy ra khi ăn phải nấm mốc - Mold ?
Sự biến đối kì diệu của nấm móc
Sự biến đối kì diệu của nấm móc
 Nếu bạn vô tình ăn phải nấm mốc thì sao?
Nếu bạn vô tình ăn phải nấm mốc thì sao?
 Thử nghiệm sự sinh trưởng của nấm mốc với UV-Pro
Thử nghiệm sự sinh trưởng của nấm mốc với UV-Pro
 VTC14 | Vấn nạn nấm mốc trong nông sản
VTC14 | Vấn nạn nấm mốc trong nông sản
 Mould Time-lapse - The Great British Year: Episode 4 Preview - BBC
Mould Time-lapse - The Great British Year: Episode 4 Preview - BBC
 Nguy hại từ việc sử dụng nông sản nhiễm nấm mốc
Nguy hại từ việc sử dụng nông sản nhiễm nấm mốc